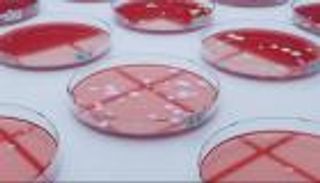
تقرير دولي: وفاة عشرات الملايين بسبب البكتيريا بحلول 2050

ثروة زميله 100 مليون استرليني.. نهاية مؤسفة لبول ديانو مغني فرقة «آيرون ميدن»

توفي بول ديانو، المغني السابق لفرقة "آيرون ميدن"، وحيدا في شقة سكنية متواضعة بعد سلسلة من المشكلات الصحية التي واجهها في سنواته الأخيرة.
اشتهر ديانو، 66 عاماً، بإسهاماته في ألبومي آيرون ميدن الأولين اللذين حققا نجاحًا كبيرًا، حيث بيع منهما أكثر من 9 ملايين نسخة.
ورغم هذا النجاح، اضطر ديانو للتخلي عن حقوقه في العوائد مقابل مبلغ زهيد يُقدَّر بـ50 ألف جنيه استرليني بعد طرده من الفرقة في سن الثالثة والعشرين بسبب تعاطيه للمخدرات وعدم قدرته على التوفيق بين أسلوب حياته الصاخب ومتطلبات العمل.

في الأسبوع الماضي، عثر الممرضون على ديانو ميتًا في شقته، بينما كان زملاؤه السابقون من الفرقة يؤدون حفلاً كبيرًا في الولايات المتحدة أمام جمهور تجاوز 20 ألف شخص، حيث قاد المغني الحالي للفرقة، بروس ديكنسون، الجمهور في لحظة صمت تكريمًا لزميلهم الراحل، معبرًا عنه بأنه "كان مخلصًا لموسيقى الروك حتى آخر لحظة في حياته"، بحسب صحيفة "ديلي ميل" البريطانية.
عاش ديانو في السنوات الأخيرة في ظروف قاسية، حيث احتاج إلى تنظيم حملة تمويل جماعي مع المعجبين لتغطية تكاليف علاجه الطبي في كرواتيا بسبب حالته الصحية الحرجة، مما ساعد في جمع حوالي 20 ألف جنيه استرليني.
على النقيض، يعيش زميله الحالي في الفرقة، ديكنسون، في باريس، وتُقدَّر ثروته بـ100 مليون جنيه استرليني، بينما يعيش عازف الجيتار ومؤسس الفرقة، ستيف هاريس، في جزر البهاما بعد أن كان يمتلك قصرًا فاخرًا في إنجلترا.
ظل ديانو صريحًا حول ظروف طرده من الفرقة في عام 1981، حيث اعترف بأن نمط حياته المدمر وتعاطيه للمخدرات أدى إلى إلغاء العديد من الحفلات أثناء الجولات.
aXA6IDIxNi43My4yMTYuNDMg
جزيرة ام اند امز